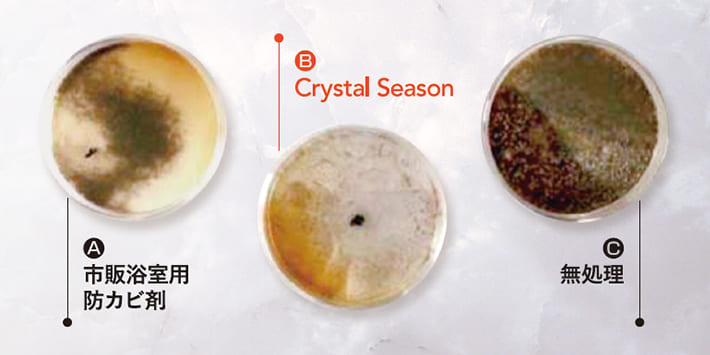

外壁塗装をお考えの方へ

- せっかく塗装するなら長持ちする塗料を選びたい
- きれいな見た目が長続きする塗料が知りたい
- 抗菌・抗ウイルスで清潔な家で暮らしたい


Crystal Seasonは人体に無害で防カビ殺菌性能が飛躍的に向上した、しかも機能が長期的持続的な防カビ殺菌コーティング剤「光触媒コーティング」を使用しています。この機能を有した防カビ触媒コーティング剤の開発は世界で初めて成功しました。光触媒コーティングの成分は、フッ素系イオン交換樹脂と銅および銀を組み合わせて出来ています。
-


どのような細菌・ウイルスに対しても不活性化が有効です。コロナウイルス、インフルエンザやMARS、アルコール耐性のあるノロウイルスやロタウイルスなど、感染対策に強いです。
-


光触媒コーティング層が、汚れやカビの発生を防ぎます。また可視光応答型により、LEDや蛍光灯でも光触媒反応を発揮し、銅イオン・銀イオンによる金属由来の抗菌作用を暗所でも発揮します。



外装塗装にとって、太陽は紫外線によって塗膜を劣化させてしまう存在です。ところがこの紫外線の力を利用して外壁の表面をきれいに保ち、さらに環境浄化まで行ってしまうのが「光触媒」です。
光触媒(二酸化チタン)に紫外線が当たることにより、活性酸素が発生します。この活性酸素が有害化学物質を分解・無害化することができ、また光触媒コーティング面が親水性(撥水性の逆)になるため、雨があたると重力により外壁などに付着している汚れを洗い流します。
光触媒は太陽光によって反応するのではなく、紫外線で反応します。そのため、日陰でも隣接する建物との距離が1m以上あれば問題ありません。また、大気中の汚染物質を光触媒作用で除去して空気をきれいにしてくれます。

光触媒に紫外線が当たることで活性酸素が発生。
活性酸素のチカラで、外壁についた汚れを分解してくれます。

超親水性により雨水などで汚れを流し落とします。



光触媒と言ったら空気清浄機能と言われるくらい、環境にやさしいことで知られています。その浄化機能は「35坪の建物へ光触媒コーティングを行うと、ポプラの木20本分に相当する」と言われています。また遮熱効果もあるので省エネ・節電により大気への放熱を抑えることができ、地球温暖化現象抑制にも貢献できます。
※この空気清浄の効果については、JIS(日本工業規格)できちんと認められ、性能評価が行われています。



アポロ計画の時代から宇宙船の燃料電池に採用されてきました。
Crystal Seasonの成分は、ひかり・ナフィオン(フッ素系イオン交換樹脂)・銅および銀を組み合わせてできています。
主成分の一つである「フッ素系イオン交換樹脂」は、高度にフッ素化が進んだフッ素樹脂でありながら親水性であり、化学的に安定でもあることから、アポロ計画の時代から宇宙船の燃料電池に採用されてきた実績があります。しかもこれは膜を形成して耐水性を発揮しながらも、結晶水を安定的に保持するという不思議な性質も併せ持ちます。
他方、銅や銀は古代より食器として同時に強い殺菌力があることがわかっていましたから、殺菌剤や保存液の必須成分として広く使われてきました。


-



外壁の色あせの原因となる紫外線を最大70%カット。退色を防ぐとともに、外壁の耐久性も高めます。また、透明性が高いため壁素材の美しい質感や塗膜の質感を損なうことがありません。
-



自動車の排気ガスや工場から排出される煙に含まれる空気汚染物質を分解する効果があります。
-



紫外線が外壁に付着した汚れを分解し、雨水が壁の汚れの下に入り込み汚れを浮き上がらせて流します。可視光応答型&超親水性で美観を長期的に保持します。
-



塗膜の対候性と低汚染性のパフォーマンスを高め、塗り替え周期を遅らせることに貢献します。
-



除菌・抗菌・抗ウイルス対策として、戸建・店舗・病院など室内にも使われております。また防臭・防カビ効果もあり、家具や建具などから出るホルムアルデヒドなど有害物質も分解します。
-



外壁の退色防止機能はもちろんのこと、さまざまな構造物への施工が可能です。住宅付帯部位でいえば、瓦・サッシ・雨樋・庇・手すり・笠木・タイル・カーポート屋根・外塀等、多岐にわたります。





これらの試験は公的機関である(財)日本食品分析センターで行っていますので、証明書も発行・付与されています。
光触媒関連のコーティング液の中では、現在世界で唯一「実用に活かせる防カビ機能を有する」製品です。

Sabouraud寒天培地の内面に塗布後、Incubatorで28℃・72時間培養。
種菌としてCladosporium混合菌を採用し、はじめに各培地シャーレに20mg添加しました。
【C】は当然ながら、全面にびっしりと黒カビが繁殖。
【A】もある程度の繁殖が見られ、市販の防カビ剤には強力な機能が期待できないことがわかります。
【B】(Crystal Season)はそれらに比べて卓越した性能が明らかとなっています。




瓦屋根の右半分に塗布し、11ヶ月後にATPを測定。塗布部分の計測値は非塗布部分の役1/3で、目にはまだ見えませんがカビの生育が十分に抑制されています。


【A】:カビの映えたコンクリート面の半分に塗布して放置。清掃や除カビ作業なしでも約5ヶ月でカビの色素が脱色する現象が確認できました。
【B】:青カビの生えた石を採取し、右半面に塗布した3日後の写真。A同様、掃除や除カビ処置をしなくてもカビが脱色しています。


石灰岩の外壁材に塗布して7カ月経過。一部洗浄のみの非塗布面では青カビの繁殖が始まっていますが、塗布面では完全に抑えられています。


右半面に塗布し、約1年経過。親水性が高いためセルフクリーニング機能もありますが、ATP検査ではカビの生育もよく抑止していることがわかります。有機汚れはカビの温床でもあるため、これは銅・銀イオンと超親水性の相乗効果と言えます。


遮熱塗料を施工した民家の屋根北側に、黒カビ・青カビが繁殖して遮熱機能が台無しに。遮熱塗料には「カビ止め剤含有」が謳われていましたが、2年以内で【A】の状態に。軽い水洗クリーニングの上、Crystal Seasonを施工。以来、そのような現象は完全に抑えられています。【B】は15ヶ月後のもの、【C】は17ヶ月後のものです。



Cristal SeasonⓇ(NFE2)は、最高度にフッ素化されたフッ素樹脂だけを用い、長期にわたる対候性を必須とする外壁用防カビ性光触媒コーティング剤として開発されました。

QUV促進耐候試験機(Q-Lab社/60ヶ国以上の導入実績を持つ対候性試験機の世界的メーカー)は、世界中で稼働している耐候試験機の中で世界トップのシェアを持ち、JIS、ISO、ASTMなど標準的な国際的工業規格に適合した最も信頼性と再現性のあるグローバルスタンダード対候性試験機であります。紫外線・結露・熱の3要素劣化を再現し、屋外で数か月あるいは数年に亘って起こる劣化を数週間という期間で再現することができます。



屋外曝露試験場は、岡山県曝露場に加えブルネイ大学キャンパス内にも確保しています。北緯5°とほぼ赤道直下の熱帯雨林に属する過酷な気候で、屋外曝露は日本と比べ5~8倍の加速が期待されます。適切な基板上で、NFE2は20年をはるかに超える優れた耐汚染性と耐久性を有します。
 この特許を取得しているのはクリスタルシーズンのみ!
この特許を取得しているのはクリスタルシーズンのみ!

日本特許(光触媒塗料組成物およびそれを用いた塗装方法)

米国特許(コーティング組成物)

40年以上も光触媒の研究を続けてきた
「フッ素樹脂施工&光触媒塗料開発のスペシャリスト」

大阪大学大学院後大日インキ株式会社(現DIC)フッ素樹脂塗料の研究に携わってきた。
その後独立し2000年に『打ちっぱなしコンクリートフッ素描画工法の開発』でNBK大賞受賞。

- 2006年
- 『フッ素樹脂光触媒の発明』Plunkett賞、発明大賞、りそな新技術賞大賞受賞。
- 2015年
- ブルネイ大学教授に就任(光触媒専門)。
- 2017年
- ケミカル・テクノロジー設立。
日本建築防カビ協会理事長。

- Rule1世界初の特許技術の習得
- Rule2地域で取り扱いは最大5社まで
- Rule3提案時の徹底説明責任の遵守
- Rule4職人への徹底的な施工研修
- Rule5施工保証書の発行
- Rule6メーカーや販売店の承認
- Rule7光触媒の正しい知識をお伝えする!




除菌・消臭・防カビ・抗ウイルス・空気浄化などの効果により、室内を快適で安全な空間へ。テーブル・イス・壁紙・漆喰・天井・床・便器・カーテン類やガラスなど、隅々まで施工可能です。


ご利用される方々へ「安心・安全」を見える形にするため、「除菌・抗ウイルス・光触媒コーティング施工証明書」および「抗菌・抗ウイルス施工済みシール」の2つの施工終了の証明書を発行します。見えるところにぜひ掲示してください。












